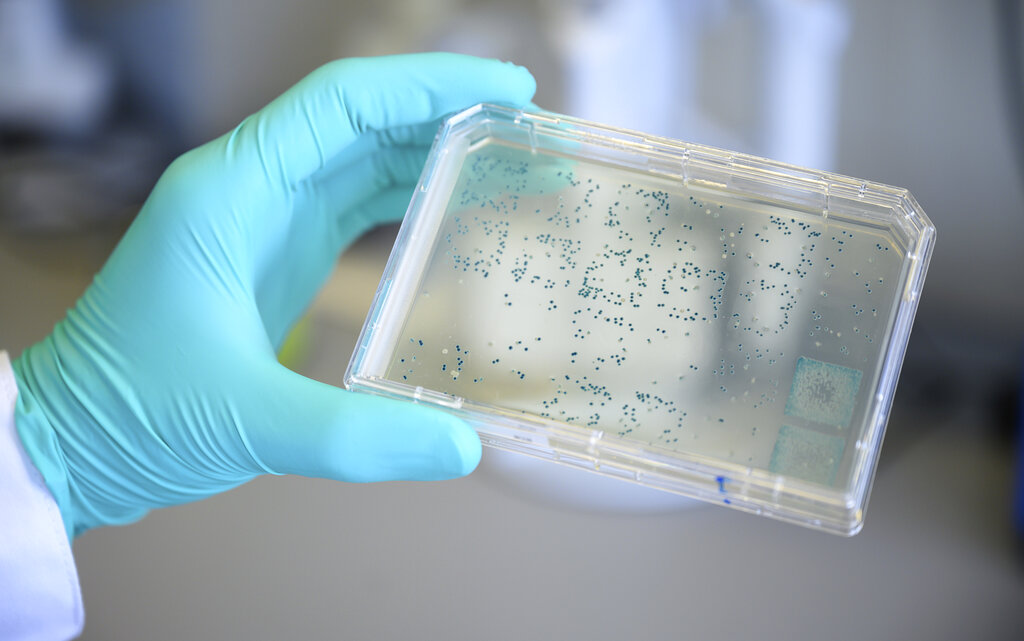
Escherichia Coli: cos’è, sintomi e come si trasmette Escherichia Coli: cos’è, sintomi e come si trasmette

Dopo tante polemiche è arrivata la prima vittima delle acque della Senna ai Giochi olimpici di Parigi 2024. La triatleta belga Claire Michel si è ammalata di Escherichia coli dopo aver partecipato alla gara femminile di mercoledì. Ma cos’è esattamente questo batterio? Ecco tutto quello che c’è da sapere.
Escherichia coli: cos’è
Escherichia coli è una specie batterica che vive normalmente nell’intestino umano e in quello degli animali. Si trova naturalmente anche nell’ambiente, nelle acque e negli alimenti. Sebbene la maggior parte dei ceppi siano innocui per la salute umana, alcuni sono invece dotati di caratteristiche particolari che li rendono in grado di causare malattia, talvolta anche grave, come per esempio gli isolati di E. coli produttori di Shiga tossina (STEC).
I sintomi
I sintomi dell’infezione intestinale da Escherichia coli comprendono: dolore addominale, diarrea (anche sanguinolenta), nausea e vomito, febbre. I sintomi compaiono generalmente da 12 ore a qualche giorno dopo il contatto con il batterio e hanno la durata di 1 settimana circa. È molto frequente che il contagio avvenga in tutte le situazioni che presentano condizioni igienico-sanitarie precarie. L’infezione da E. coli può localizzarsi anche in altri organi, causando cistiti e infezioni delle vie urinarie, ma anche quadri più pericolosi e, per fortuna più rari, di polmoniti, meningiti e gravi quadri di setticemia.
Come si trasmette?
La trasmissione del batterio avviene attraverso acqua o cibo contaminato non cotto, ma è possibile trasmetterlo anche con il contatto oro-fecale da persona a persona.
A quali esami sottoporsi
I pazienti con diarrea persistente e di forte intensità possono effettuare una coprocoltura per determinare la presenza del batterio nell’intestino. L’infezione alle vie urinarie causata da Escherichia coli è molto comune e, se adeguatamente trattata, non pericolosa, e si identifica con una urinocoltura.